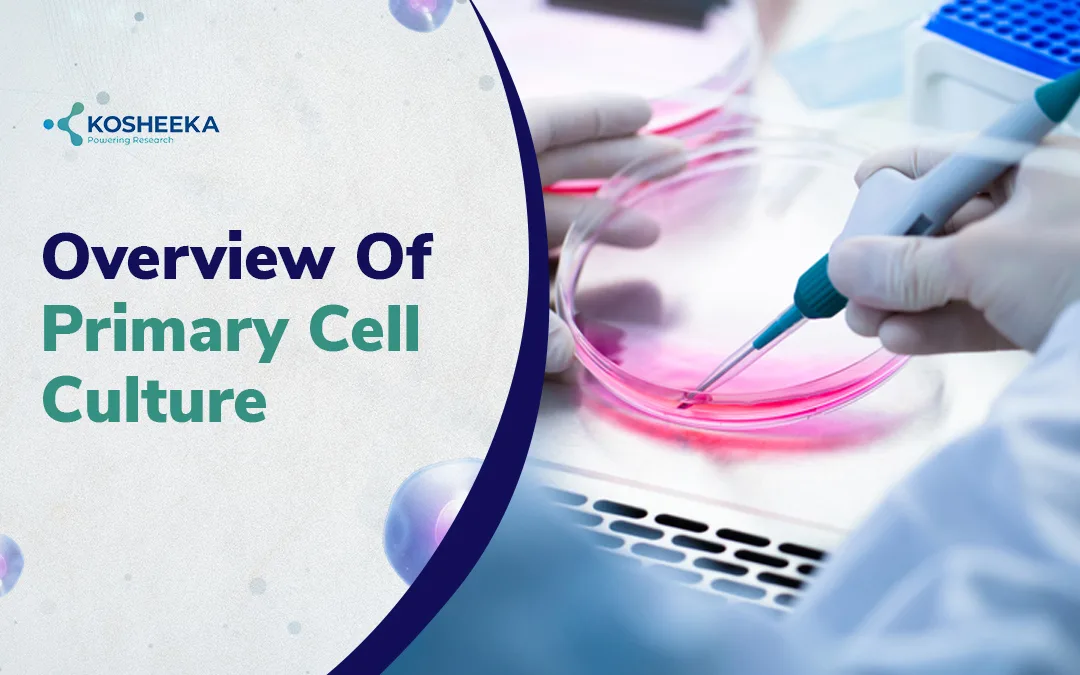

Introduction
Primary cell culture stands at the forefront as an in-vitro research model contributing to core biomedical research.
Primary cell culture involves cell isolation directly from multicellular organisms. It closely mimics the physiological state of the cells in vivo and produces related data. The mammalian tissue is derived from distinct embryonic germ layers, including ectoderm, endoderm, and mesoderm. These layers give rise to various cell types such as skin, blood vessels, blood, muscles, neuronal network, etc.
The primary cell culture in biomedical research has seen a boom during the early 20th century, when in 1907 Ross Granville Harrison cultured frog nerve fiber. The technique evolved after the 1940s after discovery of antibiotics. In modern times, Primary Cell Culture serves as a crucial research model as it facilitates researchers and scientists to replicate native tissue in controlled laboratories.
Biological Basis of Primary Cell Culture
Primary cells are derived from original organ tissue, so they exhibit normal physiology similar to the in vivo state. Researchers widely use primary cells in various studies, including metabolic studies, molecular signaling, aging, disease mechanisms and progression, therapeutics, etc. The key characteristics of primary cell culture include:
- Isolated directly from the source (human or animal)
- Maintains native morphology, gene expression profiles and functional phenotypes specific to the tissue origin
- Exhibits a finite lifespan and undergoes replicative senescence at early passages.
- Possess specific biomarkers and molecular pathways.
- Culture requires a complicated environment, shows high sensitivity to environmental factors (growth medium, humidity, macronutrients, micronutrients, extracellular matrix components, etc) [1]
Types of Primary Cells Used in Research
The widely used primary cell culture types used in research include epithelial cells, keratinocytes, blood cells, muscle cells, mesenchymal stem cells, etc. The genetic transformation of primary cell culture types includes:
- Epithelial Cells: Astrocytes, chondrocytes
- Endothelial Cells: Hepatocytes, Adipocytes
- Fibroblast: Skeletal muscle, Synoviocytes
- Immune Cells: peripheral blood mononuclear cells, macrophages, T-cells, B-cells, Neutrophils
- Keratinocytes: Smooth muscle cells, Hair
- Melanocytes: Osteoblasts, Blood cells (RBCs, WBCs)
- Neurons: Myocytes, Stem cells
Primary Cells vs Cell Lines
Seven key perspective of Primary cells vs cell lines:
| Properties | Primary Cells | Cell Line |
| Source | Isolated directly from animal or human tissue | Primary cells transformed into cell line |
| Biological Relevance | High resemblance | Low |
| Lifespan/Proliferation Capability | Short (upto 1-3 passage), Limited lifespan | High (21-50 passages), Infinite lifespan |
| Consistency | Medium | High |
| Genetic and Physiological Relevance | Retains actual characteristics (genetic and physiological relevance) with original tissue | Subject to mutation or genetic drift. The higher passage no. are more likely to loss physiological relevance or genetic resemblance |
| Ease-of Use | Complex and requires optimisation with each culture | Relatively easy, culture condition follows well-established protocol |
| Time & Cost | Cells grow at slow pace, higher cost | Faster cell growth, involves low cost |
Primary Cell Culture Procedure: Key Steps
The Primary Cell Culture Protocol involves a multistep process. The key steps include:
- Tissue Acquisition: Tissue procurement from donor organisms under sterile conditions. Tissue immediately washed with 1X PBS.
- Disaggregation: Collected tissues are subjected to mechanical and enzymatic dissociation. Tissues minced into tiny pieces (1 mm3) followed by enzymatic dissociation (collagenase, trypsin). This helps in single cell isolation.
- Filtration & Centrifugation: The digested cells are filtered via a 40–100µ filter to remove larger particles. The cells are washed with 1X PBS and centrifuged to obtain a cell pellet.
- Growth Medium: Typically consists of all macronutrients and micronutrients. E.g. Culture medium (DMEM)+ 10% FBS + 1% antibiotic
- Cell Seeding: The pellets are resuspended in fresh culture medium and seeded in appropriate culture vessels (flask, petri dish). The adherent cells are poured in an ECM coated surface, while suspension cells are seeded in a non-coated flask.
- Incubation: The cells are incubated at 37°C, 5% CO₂ and a humidified environment
- Monitoring: The cells are monitored at appropriate time intervals to ensure attachment, growth and proliferation and absence of contamination. Growth medium changes at a specific interval (≈2 days)

Advantages and Disadvantages of Primary Cells
Advantages
- Physiological and genetic relevance, chromosome numbers, and predictive accuracy
- An effective model for unveiling the underlying molecular mechanism in human disease
- Improved translational potential, suitable for drug toxicology studies, new drug development, etc.
- Less reliant on animal experiments, which relatively reduces experimental loss
- Closely resembles in vivo cell biology.
Disadvantages
- Requires a complex growth condition and has limited growth potential
- Limited lifespan, reaches cellular senescence early
- Variability based on distinct donor, behave differently in the presence of similar stimuli, batch-to-batch inconsistency
- Low yield and scalability issues, difficulty in gaining experimental result replicates
- High risk of contamination, stringent quality control protocol required
- High cost in comparison with maintaining a cell line
Applications in Biomedical Research
- Disease Modeling: Studying various disease mechanisms by replicating disease physiological conditions (cancer, neurodegenerative disease, cardiovascular diseases)
- Drug Discovery: Assess the cytotoxicity, safety, drug metabolism, shelf life, excretory pathway, etc. of a new drug molecule
- Immunological Studies: Understand immune response and find immunotherapies
- Angiogenesis and Vascular Biology: Test model for new blood vessel formation and vasculature
- Regenerative Medicine or Personalized Medicine: Understanding and developing stem cell therapy, exosome therapy and the development of personalized medicine as per the patient’s need
- Vaccine Production: Used for vaccine production in viral diseases (polio, COVID-19, Influenza, Flu, Rabies, chickenpox, etc.)
*The primary cell used for research application must be of superior quality. Kosheeka, India, is a GMP-certified research laboratory that isolates and maintains high-quality cells for research purposes.
Advances and Innovations in Primary Cell Culture
Development of 3D Culture Systems and Organoid Model
- 3D culture development resembles actual animal tissue
- Organoids mimic the organ function
- Suitable for studying diseases and developing therapeutics
Co-Culture Models
- Researchers grows heterogenous cell population
- Recreates microenvironment, shows the interaction of how the body reacts, and the immune cell response
- Stimulates blood flow
Integration with Omics Technologies
- Acts as advanced tools like genomics and proteomics research
- Uncover the mechanism that is occurring in cells at the cellular and molecular levels
- Support the identification of precise diagnostic and prognostic biomarkers
High-Throughput Screening
- Scales up experiments and improves reproducibility
- Rapid, automated evaluation of the molecule of interest on physiologically relevant cells
Ethical Considerations in Establishing Primary Cell Culture
The ethical and regulatory considerations in establishing primary cell culture include:
- Informed consent for human tissue sourcing
- Maintaining biobanking and data integrity
- Compliance with research guidelines
Future Perspectives
- Advanced 3D culture or organoid model
- Precision medicine and regenerative research
- Microfluids and organ-on-a-chip technology development
- Personalized medicine discovery, development of an advanced disease model
Conclusion
Primary cell culture has multifold applications in investigative biological research. They are outstanding models for understanding intercellular and intracellular communication, disease mechanisms, diagnostic markers, drug discovery, vaccine production, gene therapy, etc. The use of primary cell culture is an effective model for researchers to uncover complex molecular mechanisms, disease pathways, and therapeutic responses.
References
- Harper JM. Primary cell culture as a model system for evolutionary molecular physiology. International Journal of Molecular Sciences. 2024 Jul 19;25(14):7905.
FAQ’s
Q- What is the Application of Primary Immune Cells?
Primary immune cells include T-cells, B-cells, macrophages, monocytes, NK-cells, etc. In biomedical research, these calls aid in the development of immunotherapy. The cells are used in research including immune response, immunosurveillance, immunotherapy, etc.
Q- What is the Application of Primary Endothelial Cells?
Primary endothelial cells includes HUVEC, HAoEC, HDMEC, or HCAEC. These cells are responsible for regulating vessel tone, blood coagulation, permeability, etc. The major research application includes angiogenesis, wound healing mechanisms, inflammation, cancer metastasis, etc.
Q- What are the Key Advantages of Primary Cell Culture?
Primary cells resemble the physiological, genetic makeup, and chromosome number of the source. These cells enable studying signalling accuracy, molecular mechanisms, tissue-specific studies, drug development, preclinical studies, etc.